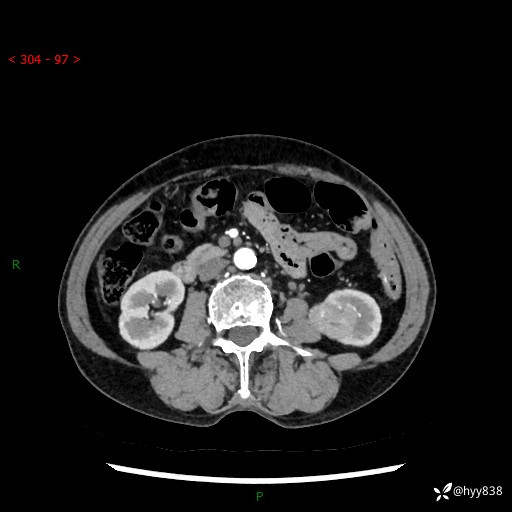
img

72岁/女,检查发现左肾占位1天。为了满足诊断,常规四期后,又加了延迟期-结果公布~
病例信息
【患者信息】:72岁/女
【主诉】:检查发现左肾占位1天
【现病史及既往史】:患者于1天前检查发现左肾占位,无畏寒发热,无咳嗽咳痰,无腰腹部疼痛不适,无肉眼血尿、无尿频尿急症状,起病来,患者未行特殊治疗,为求进一步诊治,门诊以"左肾占位"收治入院。 发病来患者精神、饮食、睡眠良好,小便如上,大便正常,体重无明显变化。
【检查】:肾脏CT平扫+增强
























【临床诊断】:
【治疗经过及结果】:
病例信息
【患者信息】:72岁/女
【主诉】:检查发现左肾占位1天
【现病史及既往史】:患者于1天前检查发现左肾占位,无畏寒发热,无咳嗽咳痰,无腰腹部疼痛不适,无肉眼血尿、无尿频尿急症状,起病来,患者未行特殊治疗,为求进一步诊治,门诊以"左肾占位"收治入院。 发病来患者精神、饮食、睡眠良好,小便如上,大便正常,体重无明显变化。
【检查】:肾脏CT平扫+增强

【临床诊断】:
【治疗经过及结果】:
